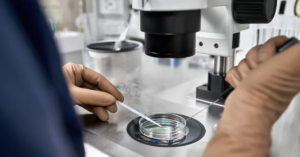

Cf68 bắn cá cổ điển online chuẩn xác dễ thắng phần thưởng
Trải nghiệm Cf68 bắn cá cổ điển online giúp người chơi tận hưởng cảm giác...
Th3
Bongvip – Xây Dựng Chiến Thuật Với 3 Bước Đơn Giản
Xây dựng chiến thuật là yếu tố quan trọng giúp nâng cao hiệu quả trong...
Th3
Cf68 bắn cá cổ điển online chuẩn xác dễ thắng phần thưởng
Trải nghiệm Cf68 bắn cá cổ điển online giúp người chơi tận hưởng cảm giác...
Th3
CF68 lô đề hiện đại phân tích chuẩn xác tỷ lệ ăn cao
Lô đề hiện đại đã thay đổi cách chơi truyền thống, giúp người chơi không...
Th3
Bongvip kinh nghiệm soi kèo bóng đá chuẩn xác cho người mới
So với việc theo dõi trận đấu thông thường, việc soi kèo bóng đá yêu...
Th3
Công Dụng Chữa Bệnh Của Mỡ Lợn
1. Giới thiệu chung về mỡ lợn Mỡ lợn là một loại thực phẩm phổ...
Th4
Hà Lan chấn động: Nguy cơ hôn nhân cận huyết từ 3.000 người với 25 anh chị em cùng cha khác mẹ
1. Giới thiệu Gần đây, Hà Lan đã rúng động bởi bê bối liên quan...
Th4
Camera Lớp Học: Cử Chỉ Nhỏ Của Cô Giáo Gợi Cảm Xúc Mạnh Mẽ Với Phụ Huynh
1. Giới thiệu chung Tình cảm giữa giáo viên và học sinh trong giai đoạn...
Th4
Rà Soát Sữa Giả Tại Hà Nội: Gần 600 Nhãn Hiệu Phát Hiện, Nguy Cơ Đối Với Người Tiêu Dùng
Giới thiệu Trong thời gian gần đây, việc rà soát sữa giả đang diễn ra...
Th4
Bí Quyết Sống Thọ Của Nữ Danh Y 103 Tuổi: 5 Nguyên Tắc Đơn Giản Nhưng Hiệu Quả
Giới thiệu Giới thiệu về danh y Chu Nam Tôn. Độ tuổi và tầm quan...
Th4